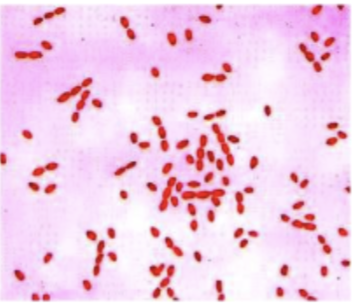
<p>What do you see under the microscope? </p>

1/32
Looks like no tags are added yet.
Name | Mastery | Learn | Test | Matching | Spaced | Call with Kai |
|---|
No analytics yet
Send a link to your students to track their progress
Reminder question: Enteric collibacteriosis of calves caused by EHEC leads to
Malabsorption/maldigestion diarrhea

What are some environmental conditions that can cause opportunistic infections
1.Overcrowding (shelter, CAFO)
2.Mixed species
3.Transport
4.Temperature, humidity change
5.Chemical and physical alterations to environment (cleaning, bedding)
6.Seasonality
What are some host conditions that can cause opportunistic infections
1.Immunosupression / immunodeficiency
•Stress
•Age
•Diseases
•Therapy
2.Allergy
3.Polymicrobial infections
4.Wounds
5.Microbiome alterations; antibiotic use
6.Nutritional changes
7.Anatomic predisposition
8.Genetic susceptibility
Which bacteria is an opportunistic pathogen?
What is a major virulence factor of opportunistic bacteria
Capsule, most are composed of polysaccharides, but some are composed of polypeptides

Tell me some Opportunistic enterobacteriaceae (coliform) and if they are flagellated or not. What illness do each cause?
Klebseilla pneumoniae - non-flagellated
Enterobacter aerogenes: flagellated
Proteus mirabilli and vulgaris: flagellated

How can one control some of these opportunistic E.coliforms
Elimination of environmental causes: hygiene, pasture
Immunity-colostrum uptake
Vaccine against klebsiella for dairy cattle
Antibiotics- antibiotic susceptibility testine
Pseudomonas aeruginosa, tell me about it and what type of bacteria it is. Where is it present?
Gram (-) rod
Pseudo(fake)-monas(bacteria) aeruginosa (copper rust)
Is an opportunistic bacteria
Produces diffusible pigments
Flagellated: one or more polar flagella
Present in water, soil, plants, skin, mucosa and feces
Wide range of disease across a wide range of species

Pseudomonas aeruginosa- infections
Fleece rot (dermatitis of sheep)
Ulcerative otitis media (dog)
corneal ulceration (horse)
otitis externa (dog)
HAI in humans (patients with cystic fibrosis)

Pseudomonas aeruginosa pathogenesis
1) Entry via contact with contaminated devices, water, environment/breach in host defenses
2) Colonization and replication (production of slime/biofilm)

Choose a correct statement about bacterial capsule:
Tell me about Brucella Spp, what do they infect and what does it lead to? is it zoonotic?
Gram (-) coccobacilli (cocci + bacilli)
Infects reproductive tract of mammals
Leads to abortion, infertility, arthritis
Zoonotic (febrile, chronic undulating illness)
What are some of the species of brucella and the animal they infect
B. abortus (cattle)
B. melitensis (goats, sheep)
B. suis (pigs)
B. canis (dogs)
B. ovis (sheep)
What is the pathogenesis of brucella
Intracellular
Invade macrophages → transport to lymph nodes →intermittent bacteriaemia → transport to reproductive organs and associated glands
Epididymitis, orchitis, sterility, reduced fertility
Intracellular replication in trophoblasts (abortions, stillbirth, neonatal mortality)
Chronic disease in joints (arthritis, lameness)

What do you see under the microscope?
Gram (-) coccobacilli)
Bovine brucellosis tell me about it, where it sheds? how its transmitted?
•B. abortus
•Sheds with milk (years) and uterine secretions and semen (weeks)
•Transmission:
•Ingestion of placental tissues/fluids and milk
•Inhalation
•Coital
• Through skin abrasions (Vets, wear gloves!)
•Transplacental

Difference between how bovine brucellosis infects women and male bovine?
Hard level: abortion storms (naive pregnant cows), decreased fertility, decreased milk production

How does one control bovine brucellosis
Treatment ineffective
Test and slaughter
Vaccination (S19,RB51)
Eradication efforts of brucellosis
•The National Brucellosis Eradication Program has nearly eliminated brucellosis from domestic livestock in USA
•Brucella abortus is self-sustained in elk and bison.
•Risk of transmission to cattle
Vaccination and separation as control strategy
How is Brucella abortus NOT transmitted to naive cow
1) ingested of contaminated fetal issues/fluid
2) inhalation
3) penetration through skin abrasions
4) Insect vector
5) Transplacental
4) Insect vector
How do you treat bovine brucellosis in USA:
antibiotics
Fluid replacement
cull
Uterine wash
Cull
Tell me about taylorella, the species and where it is a reservoir and how it is transmitted
T. Equigenitalis
•Gram (-) short rod-shaped (coccobacilli)
•Reservoir in external genital of stallions and mares
•Transmission
•Coitus
•Contaminated instruments
•In utero or at birth
What are symptoms of taylorella in stallions and mares and foals? how does one control this disease?
•Stallions: asymptomatic
•Mares: contagious equine metritis
•Mucopurulent discharge from vulva
•Temporary infertility (weeks)
•Many recover with no treatment
•25% becomes asymptomatic carriers
•Foals: 75% asymptomatic carriers
Control:
genital wash, irrigation (chlorhexidine)
Local antibiotics
Test!
How is contagious equine metritis (taylorella equigenitalis) transmitted)?
1) INHALATION
2) ingestion
3) coitus
4) vector
5) during parturition
3 and 5
Tell me about burholderia and the species. Is it zoonotic? How does one control?
Gram (-) rods/coccbacilli
Burkholderia mallei (pathogen)
Burkholderia pseudomallei (opportunistic pathogen)
Both intracellular invaders
Both are zoonoses!
Control in non-endemic countries: always test and slaughter
Glanders disease is from what species? who does it infect? is it zoonotic?
-Burkholderia mallei; primary pathogen
-Infection of Equidae (horses, mules, donkeys)
-Eradicated from industrialized world
-CDC`s bioterrorism agent cat. B
-Zoonosis (vets, farmers)
Tell me about symptoms of glanders in horses both acute and chronic?
Acute
•Mucopurulent nasal discharge
•Respiratory difficulty
•Septicemia, fever
•Death within days
Chronic
•disseminated, debilitating disease
→ nasal
→ pulmonary
→ cutaneous (farcy)
•Fatal after few months
•Survivors are carriers (respiratory, skin)
What is the control for glanders in horses
Test and slaughter
international trade control
Meliodosis, tell me about the species its from, the type of pathogen it is, where it is found, who it infects and how, transmission type, is it zoonotic? and how does one control it?
-Burkholderia pseudomallei
-Capsular- opportunistic pathogen
-Persists in soil and water
-Infects pigs, goats and sheep
-Rarely in cattle, horses, dogs, rodents, birds, primates
-Infection via inhalation, ingestion, skin contamination
-Transplacental transmission (goats)
-Zoonosis! (agricultural, aquatic workers)
-Control: test and slaughter
What does meliondosis cause and what are some clinical signs

Clinical presentation for both glanders and meliodosis
Clinical presentations:
→Localized- ulcers, nodules, abscesses,
→Pulmonary- chest pain, cough, fever (resembles TB when chronic)
→Septicemia- fatal in 80%
→Chronic infection- multiple abscesses in muscle, skin and organs (lungs, spleen, liver); debilitating illness
Person-to-person transmission is rare but can happen!
Sanitary slaughter is not required in the USA in the case of?
1) brucellosis
2) taylorella infection
3) meliondosis
4) glanders
2